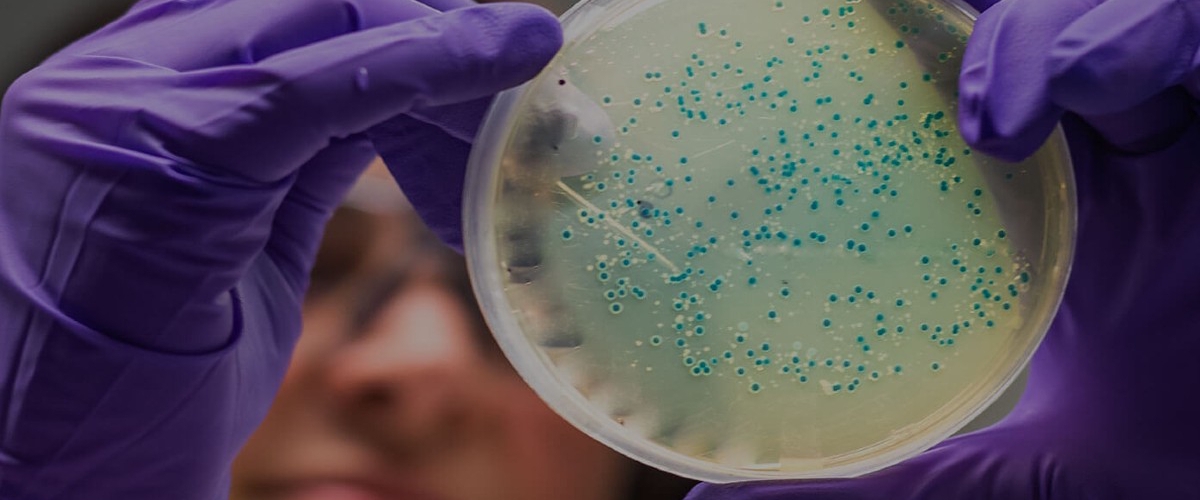
image

Трансплантация микробиоты одобрена: первый в мире метод лечения
А вот и долгожданный прорыв, причем с другого конца земного шара! Австралия официально разрешила лечить опасные кишечные инфекции, вызванные бактерией Clostridioides difficile, с помощью... пересадки микробиоты. Да-да, вы не ослышались — трансплантация донорских бактерий теперь не просто эксперимент, а утвержденная терапия. Первая в мире, между прочим.
Честно говоря, мы давно ждали этого момента. Ученые уже тоннами накопили данных о том, как пересадка кишечных бактерий спасает жизни и борется с болезнями. Эксперты из Международного сообщества микробиоты и вовсе пророчат, что за этим подходом — целая медицинская революция. Но, как это часто бывает, между многообещающими исследованиями и реальной больничной палатой лежит пропасть бюрократии. Австралия, похоже, стала первой, кто через нее перепрыгнул.
Кстати, как вообще пересаживают микробиоту? Способов — целый арсенал. Можно глотать специальные капсулы, а можно — более прямолинейно — доставить ценный груз сразу в пункт назначения с помощью колоноскопии или клизмы. Не самый романтичный процесс, но что не сделаешь ради здоровья?
В Австралии лицензию получила компания BiomeBank, которая будет работать как раз с «прямыми» методами — теми самыми колоноскопиями и клизмами.
«Весь фокус в дозе, — объясняет технический директор BiomeBank Сэм Форстер. — За одну такую процедуру мы доставляем просто гигантское армию полезных бактерий. Пероральные капсулы пока столько «войск» перевезти не в состоянии».
У компании уже есть что-то вроде банка доноров — тщательно отобранные здоровые люди, чья микробиота считается эталонной. Но ученые смотрят еще дальше: они мечтают создавать идеальные бактериальные коктейли сами, культивируя нужные штаммы в лабораториях. Представьте: будущее, где вам подбирают микробиом, как лекарство по рецепту.
И волна пошла! Вслед за Австралией активные дискуссии начались и в США. Консультанты FDA уже качают головой в знак одобрения. Мир явно дозрел.
А чтобы донора подбирать было проще, итальянские исследователи создали умный алгоритм. Он анализирует данные и с высокой точностью предсказывает, чья микробиота лучше всего приживется у конкретного пациента. Это же ключ к успеху всего лечения!
И ведь дело не только в одной инфекции. Взгляните на последние исследования: ревматоидный артрит, болезнь Паркинсона, ожирение, даже тяжесть перенесенного инсульта — у всех этих бед, кажется, есть общий корень в нашем кишечнике. Неудивительно, что за бактериями внутри нас теперь охотятся так активно.










